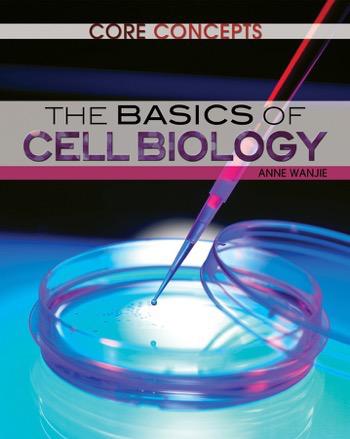

Core Concepts: Biology
These instructive volumes support Common Core science standards (such as use of math, scientific questioning, data collection strategies, evaluation of evidence, understanding scientific theories, and connecting and relating knowledge) with content that inspires thinking, reading, writing, and discussion among students. Fundamental life-science concepts are enlivened by the vivid photographs, instructive illustrations, and informative sidebars. These include "Try This" panels that provide readers with safe experiments to perform, "What Do You Think?" boxes that ask students questions that assess their reading comprehension skills, and "Applications" panels that explain how biological knowledge improves daily life and technology. Each volume includes the biography of an acclaimed scientist and a timeline of that biologist's life and work.
















